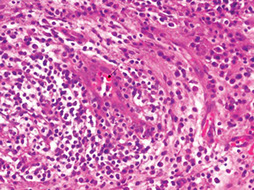
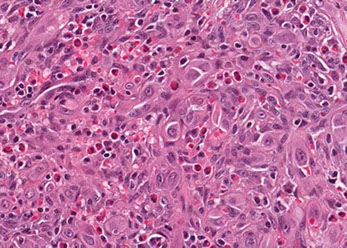
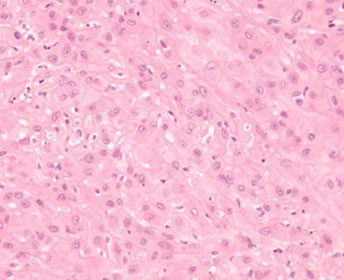
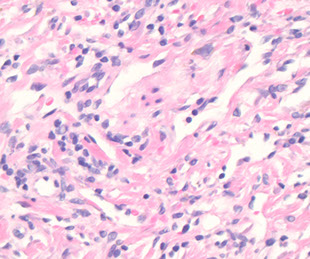

Blood Vessels
Vascular Pathology
Emboli
Deep Vein Thrombosis (DVT)
Hypertension-induced changes
Varicose Veins
Aortic dissection
Aneurysm of AV fistula
Antiphospholipid syndrome
Large vessels
Temporal (giant cell) aortitis / arteritis
Takayasu's arteritis
Medium Vessels
Kawasaki disease
PAN
Thrombangitis obliterans (Buerger's disease)
Small vessels
Henoch-Schonlein purpura
Cryglobulinemia
Lupus vasculopathy
Goodpasture
ANCA vasculitides
- Granulomatosis with polyangiitis (Wegener's granulomatosis)
- Eosinophilic granulomatosis with polyangiitis (Churg-Strauss syndrome)
- Microscopic polyangiitis
Hypocomplementemic Urticarial Vasculitis
Sturge-Weber disease
Hypersensitivity vasculitis
Raynaud's disease
Telangiectasia
Segmental mediolytic arteriopathy
Hemangiomas
- Infantile Hemangioma
- Cherry angioma
- Cavernous hemangioma
- Epithelioid hemangioma
- Microvenular hemangioma
- Spingle cell hemangioma
Pyogenic granuloma
Lymphatic Malformations
Hemangioendothelioma
Epithelioid / histiocytic hemangiogenothelioma
Kaposiform Hemangioendothelioma
Epithelioid Sarcoma-like Hemangioendothelioma
Glomus tumor
Perivascular Epithelioid Tumor (PEComa)
Bacillary angiomatosis - Infectious Dermatopathology
Angiokeratoma
Atypical Vascular Lesion (AVL)
Angiosarcoma
Kaposi sarcoma
Lymphangiosarcoma
Venous lake
Emboli
Fat, Air, Thrombus, Bacteria, Amniotic fluid, Tumor
*** FAT BAT ***
- Fat emboli assoc w long bone fx and liposuction
- Amniotic fluid emboli may lead to DIC, esp postpartum
- Pulmonary Embolus: chest pain, tachypnea, dyspnea
~ approx 95% of pulmonary emboli arise from deep leg veins
Vasoconstrictors (ie serotonin) released from platelets --> inc PVR --> V/Q mismatch at areas other than the site of the embolus
Dx: Angiography most accurate, but have a 0.5% mortality rate; therefore CT angiogram (spiral CT) is standard of care
- if CT completely normal, V/Q scan may be able to exclude clot (like D-Dimer in DVT)
May see lines of Zahn microscopically
inc A-a gradient: Ventilation > blood flow --> inc anatomic dead space
- air doesnt participate in gas exchange --> inc physiologic dead space
Tx for acute hemodynamic instability or saddle embolus: Thrombolysis w interventional radiology
Deep Vein Thrombosis (DVT)
Virchow's triad: 1) Hypercoagulability 2) Stasis 3) Endothelial damage
- inc perfusion at base of lungs --> inc % PE goes to base --> infarction more likely at bases
~ wedge-shaped area of infarct at pleural surface
Hx/PE : SOB + tachypnea --> Resp alkalosis and hypoxemia; pleuritic friction rub
- Homans' sign: pain w dorsiflexion of foot and tender calf muscle
Dx: Spiral CT is definitive; D-Dimer can r/o PE; may see Hampton's hump or Westermark's sign (spreading oligemia) on CXR
Tx: prevent with heparin and coumadin, min of 6 mo
- give IVC filter for someone not eligible for anticoag
Hypertension-induced changes
Caused by HTN :)
Micro: medial sm muscle hypertrophy --> intimal fibroelastosis
- sm muscle layer atrophies when elastosis becomes too profound
Plasma protein constituents (C3b) get deposited in the arteriolar wall, which gets damaged
Varicose veins
Dilated, tortuous superficial veins 2/2 chronically inc venous pressure
- may lead to varicose ulcers and poor wound healing
-- embolism formation is rare
Aortic Dissection
MC risk factor is HTN
- may be assoc c trauma, surgery, or inherited CT dz
- atherosclerosis and diabetes are also risk factors, but not as much as HTN

Aneurysm of AV fistula
An abnormal communication bwt artery and vein
Etiology: trauma, inc venous pressure
Complications: high output cardiac failure, rupture, bleeding, tamponade
Antiphospholipid (APL) Syndrome (APS)
B2-glycoprotein 1 and phospholipid abs complexes on platelets and endothelial cells circulate and cause hypercoagulable state leading to arterial and venous thrombus formation
- may be secondary to SLE; termed primary if not
Sx: repeated miscarriages, recurrent thrombi formation, PE / pulmonary HTN, TBCpenia, stroke, bowel infarctions, renal failure, cardiac valve vegetations
- catastrophic APS: <1% have systemic thrombus formation c high mortality
- miscarriages caused by ab's against trophoblasts, not by thrombus formation
Dx:
- gives false (+) in syphilis test!!
Micro: different-aged fibrin thrombi c signs of recanalization
- no significant inflam component
Vasculitides
Large vessels
Temporal (Giant cell) aortitis/arteritis
MC vasculitis in large (and medium-sized) arteries
- usually affects branches of the carotid artery (ie temporal a.) in elderly females
- affects large and medium sized branches of the aorta c predilection for the extracranial branches of the carotid artery
- giant cell arteritis may be primary in breast (GCAB), where it can mimic ca or autoimmune dz (polymyalgia rheumatica)
- vasculitis is considered by some to be a paraneoplastic syndrome
Sx: unilateral headache, jaw claudication, impaired vision (may cause irreversible blindness if ophthalmic a. occluded), polymyalgia rheumatica
- note that sx all occur around the temporal artery…
- can also get aortic aneurysms
Labs: inc ESR, 50% have systemic sx and polymyalgia rheumatica
- no specific serologic markers
Micro: Fragmented elastic fibers, giant cell / granulomatous (macros and lymphos) response and intimal thickening which reduces lumen
- giant cells not required for temporal arteritis (in ~75%), only destruction of internal elastica with inflammation
-false negatives due to focal distribution and steroid tx before biopsy (3-5 cm); polymyalgia rheumatica (muscle pain)
Dx: Temporal a. bx
Tx: high-dose steroids (do not wait for bx results to tx - Emergency!!)

Giant cell arteritis of the breast. The vessel wall has been replaced by granulomatous inflammation. The process has compressed the vessel lumen to near-complete obstruction. A giant cell is shown in this field. B, Giant cell arteritis of the breast. Granulomatous inflammation and fibrinoid necrosis are shown within the wall of this vessel. C, Giant cell arteritis of the breast. The special elastin stain highlights the fragmentation of the internal elastic
lamina in this vessel (hematoxylin-eosin, original magnifications320 [A and B]; original magnification320 [C]).

Takayasu arteritis
- aka "pulseless disease" - look for young (<40 yo) Asian girls c weak pulses
- MC in Japan, China, and India c areas of high prevalence in Mexico
Sx: Weak pulses esp in upper extremities (makes the UE cold), ocular problems, skin nodules
- blood pressure difference bwt extremities
Dx: angiography
Labs: inc ESR; no specific serologic markers
Micro: granulomatous thickening of aortic arch and/or great vessel prominence
- mononuclear inflam c giant cells (similar to giant cell arteritis, the distinction is primarily based on age differences)
Medium vessels
Kawasaki disease
aka mucocutaneous lymph node syndrome
Acute, self-limiting necrotizing vasculitis in male infants / kids assoc c Asian ethnicity
- fever of unknown origin that lasts at least 5 days
- bilateral, nonpurulent conjunctivitis
- cracking of lips and strawberry tongue
- skin pealing and erythema on fingertips and palms/soles
- cervical lymphadenopathy
***CRASH and Burn! *** --> Conjunctivitis, Rash, Adenopathy, Strawberry tongue, Hand and foot edema, fever >5 days ***
*** STEAM*** --> Sterile pyuria, Thrombocytosis, inc ESR/CRP, Aseptic Meningitis
Complications: may develop coronary a. aneurysms
Tx: IVIG and high-dose aspirin
Cogan Syndrome
Vasculitis with keratitis and vestibulo-auditory symptoms
- no assoc serologic markers
Bechet disease
Oral ulcers, genital ulcers, uveitis; pathergy test positive
- incidence highest in Middle East, Far East and Mediterranean
PolyArteritis Nodosa (PAN)
Immune complex-mediated transmural vasculitis c fibrinoid necrosis of small and medium muscular arteries
- not present in arterioles, capillaries or venules
- lungs are spared
Sx: abd pain, myalgia, HTN, neurologic dysfunction, cutaneous eruptions
- involves renal vessels, nerves (monomeuritis multiplex), skin and visceral (kidneys, mesentery) vessels, though not pulmonary arteries (lungs are spared)
*** PAN = Pulmonary Arteries Normal ***
- lesions are different ages
Micro: bx shows segmental fibrinoid necrosis of inflamed arterial walls, c a predilection for branch points
- characteristic feature is segmental nature of involvement, c active and healing lesions next to normal segments of bv's
Labs: 30% have hep B seropositivity
- multiple aneurysms and constrictions on arteriogram
- No assoc c ANCAs
Tx: corticosteroids, cyclophosphamide
- same tx as Wegener's; cures 90%; fatal if untx'd
Polyarteritis Nodosa


Thrombangitis obliterans (Buergers dz)
Look for young (25-40 yo) heavy smokers that get gangrene and auto-amputation of digits, hands, etc
Sx: cold sensitivity (Raynaud's phenomenon), pain inaffected part, intermittent claudication (color changes) superficial nodular phlebitis
Imaging: no atherosclerosis, no source of thrombi
Micro: vasoocclusive inflammatory thrombus that lacks fibrinoid necrosis and doesn't involve vessel wall c intact internal elastic lamina
Labs: no specific serologic markers
Tx: smoking cessation (easier said than done)
Small vessels
Henoch-Schonlein purpura
In 50% of cases, pt is 2-11 yo c recent hx of URI (viral or GAS)
- MC childhood systemic vasculitis
Triad:
1) Palpable purpura: Skin rash on butt and legs
2) Arthralgia
3) Intestinal hemorrhage (abdominal pain)
Mech: Caused by IgA immune complex deposition
- mesangial IgA deposition can be visualized in renal dz
-- can have ARF if severe, mild HTN and nephritic syndrome more common c slightly inc Cr
- multiple lesions of the same age
Skin shows leukoclastocytic vasculitis
Labs: it is completely worthless to get serum IgA levels
Tx: Roids for severe pain or progressive renal failure (which is irreversible)
Lupus vasculopathy
- aka noninflammatory necrotizing vasculopathy
Cryoglobulinemia
Labs: hypocomplementemia, (+) Rheumatoid factor but negative ANA
- also cryoglobulins +
Plugged vessel diff: DIC, purpura fulminans
Goodpasture syndrome
Abs against a3 chain (NC1 domain) of type IV collagen causing lung and kidney damage
- aka anti-GBM disease if only damage to kidneys and not lungs
Affects smokers in 2nd/3rd decades
Sx: Hemoptysis and hematuria
- MCC death: uremia
Abs cause immune rxn that causes RPGN and necrotizing hemorrhagic interstitial pneumonitis
- assoc c HLA-DRB1*1501/1502
- normal ab's are damaged, which exposes an internal epitope that binds the a3 BM receptor
Micro: focal alveolar necrosis c intraalveolar macrophages and hemorrhage
- linear Ig deposits on BM (Not necessarily diagnostic; can be seen in diabetic glomerulosclerosis or fibrillary glomerulopathy)
Kidneys have focal proliferative GN or crescent-shaped growths that fill Bowman's space in RPGN; also see linear Ig on the GBM
- ruptures of Bowman's space can be seen c silver, trichrome or PAS
Lab: anti-GBM
Tx: Plasmapheresis (remove the insulting ab's), immunosuppression
ANCA vasculitides
- antibodies against enzymes in the cytoplasm of neutrophils (can directly degranulate / activate neutrophils)
-- hence Anti-Neutrophil Cystoplasmic Antibodies (ANCA)
- titer levels usually mimic dz severity
MCC pulomary-renal syndrome (>50%)
Anti-proteinase-3 (PR3-ANCA; formerly cANCA) - cytoplasmic staining of neutrophilic granules
- induced by infx
Anti-myeloperoxidase (MPO-ANCA; formerly pANCA) - perinuclear staining, alternative myeloperoxidase
- induced by rx (PTU)
- assoc c Churg-Strauss and microscopic polyangiitis
Abs are directed against cells and do not form immune complexes
- "pauci-immune" bc no ICs to stain in vascular cells
3 flavors:
1) Granulomatosis c polyangiitis (Wegener granulomatosis)
2) Eosinophilic granulomatosis c polyangiitis (Churg-Strauss syndrome)
3) Microscopic polyangiitis
Geographic necrosis in Wegener's

Granulomatosis with polyangiitis (GPA)
- formely (Wegener's granulomatosis)
Triad of upper respiratory tract, lung, kidney
- focal necrotizing vasculitis, necrotizing granulomas in the lung and upper airway, necrotizing glomerulonephritis
Sx: hemoptysis, nasal septum perforation, chronic sinusitis
*** the C's: Cavitary lesions, Crescentic GN, C-nose, C-anca, Cyclophosphamide, Corticosteroids ***
Micro: Fibrinoid necrosis c early neutrophils followed by macros and granuloma c giant cells
- see focal segmental necrotizing glomerulonephritis, pauci-immune type, in kidneys
- palisading necrotizing granuloma with neutrophils (stellate abscesses)
- epidermis necrotic or ulcerated
- necrosis is blue bc comes from neutrophilic microabscesses
Triad: 1) mixed inflam c GCs; 2) geographic necrosis, 3) vasculitis
Labs: (+) Anti-proteinase 3 (PR3-ANCA) by ELISA [formerly C-ANCA]
*** 3 = W ***
cANCA (+) in >90% of cases [5-20% pANCA (+)]
- Confirm Wegener's c ELISA for anti-proteinase 3 !!!
- urinalysis: hematuria and red cell casts
Imaging: large nodular densities
Tx: Cyclophosphamide, Corticosteroids
Eosinophilic granulomatosis with polyangiitis (EGPA)
- formerly Churg Strauss
- Look for vasculitis in a young asthmatic !!!
- used to be considered a variant of polyarteritis nodosa, distinguished by presence of granulomas and abundance of eosinophils
Dx criteria:
1) Asthma
2) Eosinophilia
3) Mono- / polyarthropathy
4) Migratory lung infiltrates on xray
5) Paranasal sinusitis
6) extravascular eosinophilic accumulation
Micro: neutrophilic LCV c palisading granulomas
Lab: (+) p-ANCA (anti MPO)
Complications: pts can die from coronary arteritis or myocarditis
- neurologic involvement can be debilitating
EGPA

Microscopic polyangiitis (MPA)
- similar to Wegener's, but without the granulomas; lesions are of the same age (like HS purpura)
- involves lungs and kidneys and other organs, tending to affect small arterioles and venules
Sx:
1) Constitutional sx
2) inflamed kidneys
3) skin lesions (palpable purpura)
4) Peripheral nerve damage
5) lung involvement (alveolar hemorrhage from pulmonary capillitis)
Lab: (+) pANCA (aka anti MPO; similar to Churg-Strauss)
Micro: alveolar hemorrhage, hemosiderin-laden macrophages in alveolar spaces, and neutrophilic capillaritis
MPA

Hypocomplementemic Urticarial Vasculitis
Mech: classic complement pathway activated resulting in reduced levels
Sx: Urticaria for 6+ mos, low complement levels, other systemic sx (arthralgia, glumerulonephritis [hematuria / proteinuria], obstructive pulmonary disease, GI pain)
- leukocytoclasis: fragmentation of leukocytes c nuclear debris and fibrioid deposits
IF shows Ig, complement, and fibrin deposits around blood vessels
Sturge-Weber disease
*** like a Surge of destruction through cn V1 and V2 [Weber = 2 V's] ***
Affects capillary-sized vessels
Sx: Port-wine stain (nevus flammus) on face, ipsilateral leptomeningeal angiomatosis (intracerebral AVM), seizures, early onset glaucoma, mental retardation, hemiplegia
Hypersensitivity vasculitis
Small vessel vasculidities that can manifest as rash, purpura, or have visceral involvement
- lesions of same age
- immune-complex mediated vasculidities: exogenous Ag's like drugs, food, infx
Can be part of systemic CT dz or 2/2 malignancy
Schwartzman rxn: vasculitis from 2nd exposure to endotoxin causing glomerular thrombosis
Raynaud's disease
Discoloration in distal extremities (fingers / toes) due to vasospasm in small vessels causing a dec blood flow from stress (emotional, or cold temp)
- if caused by a Mixed Connective Tissue Disease, called Raynaud's phenomenon
*** Raynaud's FAMomenon ***
Fatigue
Arthralgias
Myalgias
Tx: ASA, dihydropyradine, calcium channel blockers, sildenafil
Telangiectasia
Small vessel AVM causing dilated vessels on skin and mucous membranes
Hereditary hemorrhagic telangiectasias (Osler-Weber-Rendu syndrome)
AD inheritance of epistaxis, skin discolorations, GI bleeds, and mucosal telangiectasias
Segmental mediolytic arteriopathy
- aka segmental arterial mediolysis
Rare idiopathic nonatherosclerotic, nonvasculitic arteriopathy with degeneration of the tunica media
Spider telangiectasia (nevus araneus)
SubQ radial array of dilated (ectatic) small vessels emanating from central core that blanches when pressure applied
- assoc c inc E
Simple Lymphangioma
aka Capillary lymphangioma
Smallish (1-2 cm) non pigmented raised lesion in head, neck or axilla
- made of small capillary-like vessels (can only tell the vessels are lymphatics by their lack of RBCs, if RBCs present then it is a hemangioma)
Basic Classification of Vascular Tumors of Skin:
Benign:
- Hemangiomas
- Vascular malformations
Intermediate behavior:
- hemangioendotheliomas
Malignant
- Kaposi sarcoma
- Angiosarcoma
Hemangiomas
Infantile hemangioma
- aka cellular hemangioma of infancy, strawberry hemangioma, or (generally for hemangiomas) lobular capillary hemangioma
Elevated red lesions visible soon after birth which usually are gone by age 6 (are not same thing as port-wine stains); in ~1/20 births, 3F>1M
- usually on head and neck but can be in liver, other places
- MC ST tumor of infancy and childhood
- Hemangiomas typically made of capillary vessels in lobules, c a feeder vessel
- early on can look like birthmark and is flat red lesion that intensifies in color when baby cries
- 7-9/10 gone by age 7 years
Micro: multinodular masses c single normal arteriole, can have prominent draining vessels
- early lesions c plump endothelial cells and pericytes c clear cytoplasm that form small capillaries c small lumens
- as blood flow increases the cells become flatter and the lumens inc
IHC: (+) GLUT-1
- if GLUT-1 neg, may be of the Rapidly Involuting (RICH) or Non-Involuting (NICH) types
Genes: some may be familiar c 5q31-33
- small subset may be linked to PHACE syndrome (Posterior fossa brain malformation, Hemangioma, Arterial cerebrovascular abnormalities, Eye anomalies)
Tx: usually can be allowed to regress, but can consider surgery, roids, pulsed laser
Px: Hemangiomas virtually never undergo malig transformation, c exception of those that are irradiated
- do not met (if mets are seen, is a well-diff angiosarcoma)
Congenital nonprogressive hemangioma
Distinct from infantile hemangioma; presents at birth as a fully developed lesion; M=F; after birth lesion can remain static or rapidly involute
Cherry angioma
- aka senile angioma
Common; small red little mole c pale halo in old people that do not go away and in fact increase in number with age; usually on trunk and extremities
- may be assoc c infx or exposure to chemicals as have occurred in crops in nursing homes
Micro: lobules of capillaries lined c prominent endothelium
- dilate c age, causing elevation and mild atrophy of overlying skin
- can have a collarette like a pyogenic granuloma
Cavernous hemangioma
- aka cystic hygroma
Large (up to 15 cm) venous malformation in cavernous spaces of skin, mucosa, liver, pancreas, brain or spleen
- can involve fat and lymphatics too
- do not disappear c age
- common in Turner syndrome
Assoc c von-Hippel Lindau syndrome (RCC, hemagioblastomas, adenomas)
Epithelioid Hemangioma
- aka angiolymphoid hyperplasia with eosinophilia, or histiocytoid hemangioma
3 subtypes:
1. typical
2. cellular
3. angiolymphoid hyperplasia with eosinophilia (ALHE)
Clinically is a multinodular red / purple plaque
- often on temple (craniofacial region)
- may be secondary to trauma
- usually will see the damaged vessels in the specimen somewhere
Micro: multinodular / nodular, large component of round blue cells in background which are lymphs
- clustered vessels with plump eosinophilic endothelial cells
- also lots of eos inbackground
-- can be difficult to recognize vessel spaces on small bx
- endothelial cells hobnail into vessel lumen
Usually easy H&E dx, but can cause possible confusion with angiosarcoma if:
- small bx
- hypercellular or mitatically active
- minimal inflam or few / absent eosinophils
- non-classic clinical setting
- "penile-type" notoriously confused with angiosarcoma (cellular and atypical in appearance) - may result in terrible irreversible surgery - so should be extra cautious with penile lesions
IHC: (+) vascular markers, CD31, ERG, CD34 (to a lesser extent)
Gene: 1/3 with FOS gene abnormalities by FISH
- ALHE lacks FOS rearrangements suggesting different pathogenesis
Px: b9, no mets

Epithelioid hemangioma
Can be difficult to see vascular spaces, causing concern of angiosarcoma

Epithelioid hemangioma of the penis. A, Sections show a multinodular lesion in the dermis. B, A high-power view demonstrates pleomorphic epithelioid cells with eosinophils. C, The lesional cells are focally positive for pancytokeratin (not shown), and they are diffusely immunoreactive for erythroblast transformation-specific transcription factor (ERG) (D), with a low Ki-67 proliferation index (,5%) and (not shown) retained nuclear integrase interactor 1 (INI1) (hematoxylin-eosin, original magnifications x20 [A] and x200 [B]; original magnification x40 [C and D]).
Glomeruloid Hemangioma
Rare cutaneous hemangioma assoc c POEMS syndrome (Polyneuropathy, Organomegaly, Endocrinopathy, M protein/Myeloma, Skin (hemangiomas) and Sclerotic bone lesions)



Golumeruloid hemangioma
Microvenular Hemangioma
Slit like vascular channels that can mimic Kaposi sarcoma
- infiltrative-looking lesion that has vascular spaces growing between colagen bundles
Mciro: vascular spaces that infiltrate bwt collagen and go into the deep dermis (looks like Kaposis bc of infiltration)
- spindle lesion with compressed vascular channels
- no atypia, very few mits, blood is usually confined to the vascular spaces
Tto distinguish from Kaposi sarcoma:
- channels intercalate bwt dermal collagen but do not dissect / encompass collagen bundles
- no infiltrative proliferation of spindled endothelial cells
- minimal atypia or mitotic activity
- minimal extravasation of RBCs
- minimal inflam (few plasma cells)
- clinical history and appearance also helpful
IHC:
- neg: HHV-8
Px: B9

Microvenular hemangioma


Spindle cell hemangioma
- formerly spindle cell hemangioendothelioma (but reclassified bc of its b9 nature)
- theory of why they are multifocal is bc they grow inside large BV
Assoc c Maffucci syndrome
Micro: has 2 zones - 1 zone that looks like a cavernous hemangioma (or a cavernous malformation) and another that is more cellular (similar to Kaposi sarcoma)
- tumor grows inside large blood vessels
- despite name, can have very epithelioid cells
- has complressed slit-like spaces
- unique finding is little groups of cells that look like compressed fat cells, which is actually a group of endothelial vacuoles
- phlebolith - calcified thrombus that can be seen on imaging
Genes: IDH1 mutation in many cases
- seen in both sporadic and Maffucci assoc
- evidence that this is a true neoplasm and not a malformation
IHC:
- neg: HHV-8

Spindle cell hemangioma

Epithelioid areas in a spindle cell hemangioma




Pyogenic granuloma
Pyogenic granuloma
aka lobular capillary hemangioma or granula gravidarum (pregnancy tumor; in 1% of pregnant women, regresses after delivery), or eruptive hemangioma
Mucosal or skin lesion that grows fast, exophytic red nodule attached by stalk to skin or gingival mucosa that bleeds easily and ulcerates
- 1/3 are due to trauma, can also be from irritation or homones
- often found in gums, skin, nasal septum, possibly the thigh
- may be painful
- can be assoc c Bortonella seropositivity
- often assoc c peripheral giant cell granuloma (PGCG) and peripheral ossifying fibroma
- the name "pyogenic granuloma" misleading bc is not a true granuloma, but is actually a capillary hemangioma of lobular subtype (which is why the lesion is more prone to bleed)
Micro: lobular prolif of capillaries, epidermal "collarette", edema in stroma, acute / chronic inflam and ulceration, epidermal atrophy
- resembles granulation tissue

Lymphatic malformations
- aka cystic hygroma, lymphangioma
fairly rare, usually found in the neck / axilla and is assoc c Turner's syndrome; M=F; fluctuant mass
- seen as abnormality of morphogensesis and not a neoplasm
- subclassified as microcystic, macrocystic or mixed
Histo: has big irreg vascular spaces (like a cavernous hemangioma) and is lined by bland, flat epithelial cells to hobnailed cells
- stromal lymph aggs may be present
- not encapsulated
- can look like cavernous hemangioma if there is lots of hemorrhage
IHC: (+) D2-40 (podoplanin)
Tx: complete excision to avoid recurrence
Px: may cause fetal demise 2/2 lung compression
- can spontaneously regress
Hemangioendothelioma
Int grade vascular tumor c variable histologic features and behaviors
- 40%recur, 20% mets, 15% die from tumor
- each variant of hemangioendothelioma is not really a subtype of one disease, but rather its own distinct entity in appearance, behavior and on a molecular basis (thus :should NOT be used as a generic diagnosis)
- composite, Dabska-type, epithelioid, epithelioid sarcoma-like (pseudomyogenic), kaposiform, or retiform
-- "spindle cell hemangioendothelioma" though to be a low grade version of angiosarcoma and had distant mets, although was reclassified as benign later, and is now called spindle cell hemangioma (spindle cell hemangioendotheliomas do NOT exist);
IHC: (+) FLI-1
Epithelioid Hemangioendothelioma (EHE)




A, Epithelioid hemangioendoethelioma is composed of epithelioid cells with abundant eosinophilic cytoplasm that often contains vacuoles. B, The endothelial nature of the cells is confirmed by erythroblast transformation-specific transcription factor (ERG) staining.
Epithelioid / histiocytic hemangioendothelioma
Intermediate grade vascular malig in extremities of older adults derived from a vein (in 50%) ; arise from a small to medium-sized vessel
- most aggressive form of hemangioendothelioma (significant morbidity and mortality)
- MC in lung and liver, with a minority in ST, bone
-- sometimes more indolent when occurs in skin / ST
- can be multicentric, but no real specific clinical appearance
Gross: up to 18 cm
Micro: cords / small nests of round endothelial cells c lots of reddish cytoplasm that expand the vessels as they extend centrifugally from the lumen to the soft tissue in myxoid / mucinous sclerotic background
- blister cells c red cell fragments, which are tumor cells trying to form vascular lumens (similar to what may be seen in lobular breast ca)
-- can have vacuoles in lots of vascular tumors (blister cells are NOT specific for EHE) with plump endothelial cells
- usually does not make well-formed infiltrating vascular channels (like angiosarcoma does); good to distinguish from angiosarc
- lumen filled c necrotic debris, tumor and dense collagen
- round and possibly indented nuclei c intracytoplasmic vacuoles
- minimal mits, atypia or necrosis; though can be significant in small subset
IHC: (+) ERG, FLI1, CD34, CD31; many are keratin positive (CK+)
Genes: t(1;3)(p36;q25) WWTR1-CAMTA1 fusion (in nearly all cases)
- small subset have YAP-TFE3
- can test for FISH in difficult cases
YAP1::TFE3 fused hemangioendothelioma
•Clinical features
•F> M 17:7
•Median age 44 years (range20-78 years)
•Soft tissue (including skin) 50%, bone 29%, lung 13%, liver 8%
•Two-thirds multifocal on presentation; Distant metastasis: 7
•Follow-up, median 36 months
•35% ANED
•47% long term survival despite multifocal or metastatic disease
•88% 5 year disease specific survival
•Multinodular and infiltrative
•Patterns
•Sheets and nests separated by collagenous stroma
•Pseudoalveolar
•Pseudo or true vasoformation
•Cords and nests in myxoidstroma
Tx: low-grade - exicision c wide margins
- high grade - radical excision c dissection
Px: unpredictable (?), but not as bad as angiosarcoma
- 15% die from dz, 15% recur, up to 1/3 mets
- if has inc mits, 5 yr survival is 60%, vs low mets 100%

YAP1::TFE3 fused hemangioendothelioma



Kaposiform Hemangioendothelioma
Kaposiform hemangioendothelioma
- also Acquired Tufted Angioma
Rare, locally aggressive neoplasm of infants / kiddos in skin retroperitoneum and bone
- death from extensive dz and severe coagulopathy (Kasabach-Merritt syndrome)
- no mets
Micro: infiltrating nodules (cannon-balls) and sheets of compact spindle cells c slit-like lumina
- platelets get stuck in whorled nodular vascular channels
- has dilated lymphatic channels at periphery
IHC: (+) VEGFR-3
- GLUT-1 negative (unlike infantile hemangioma)
DDx: Acquired tufted angioma (looks identical microscopically, BUT just a small skin lesion in adults and is not assoc c KM syndrome)
Tx: may be a difficult decision to remove tumor bc of low platelets in pts
Px: 10% mortality; usually when assoc c bleeding from low platelets in KM syndrome

Epithelioid sarcoma-like Hemangioendothelioma

Epithelioid Sarcoma-like Hemangioendothelioma
- aka pseudomyogenic hemangioendothelioma
Presents as multifocal skin / subcutis / deep mscule / bone nodules on extremities
- multiple lesions in multiple tissue planes
- clinically is very worrisome for metastatic disease
•Originally described as ESH in 2003
•Subsequently re-described as PH in 2011
•M:F 3-5:1
•Multifocal disease involving multiple tissue compartments in 2/3 patients
•Relatively indolent
•High risk of local recurrence
•Rare lymph node and distant metastasis
Micro: looks a lots like epithelioid sarcoma or rhabdomyosarcoma
•Ill-defined nodules, sheets or fascicles
•Spindled to epithelioid tumor cells, often with admixed neutrophils (50%)
•Abundant, dense eosinophilic cytoplasm
•No overt vascular channels
•Positive for AE1/3, CD31 (50-70%), ERG,SMARCB1 (INI-1) retained
•Negative for CD34
IHC: (+) CK (nearly 100%), CD31, ERG, FLI-1
- neg: CD34, desmin
- nuclear INI-1 is retained (which is lost in epithelioid sarcoma)
•Cytogenetics: t(17;19)(q22;q13)SERPINE1-FOSB
•Subsets with ACTB-FOSB, WWTR1-FOSB, CLTC-FOSB fusions
•Immunostain for FOSB (nuclear positivity) effective surrogate
•Caveat: Some epithelioid hemangiomas have FOSBfusions and are positive for FOSB by immunohistochemistry
DDx: Differences from epithelioid sarcoma
•Lacks central necrosis of sometimes seen in epithelioid sarcoma
•Cells have denser eosinophilic cytoplasm
•Stromal neutrophils (when present)
•Epithelioid sarcoma has more nuclear atypia
•Epithelioid sarcoma negative for CD31, Fli-1, FOSB, and INI-1 (negative nuclei); (?ERG)
•Epithelioid sarcoma CD34+ ~50-60%
Px: may be locally aggressive but is rarely fatal (vs epithelioid sarcoma)


Glomus tumor
B9, wide age range, comes from modified sm muscle of glomus body (specialized AV anastamosis dealing c thermoregulation)
- usually under fingernails (normal glomus cells are modified sm muscle cells and are normally found on sides of digits and coccyx
- should have at least some focus of typical glomus tumor (usually at periphery)
- usually are extremely painful
- abundantly produces type IV collagen
Similar entities:
- Glomangioma: glomus tumor that looks like a cavernous hemangioma c thicker vessels; usually multiple
- Glomangiomatosis: diffuse angiomatosis that looks like angiomatosis c excess glomus cells; assoc c lots of fat)
- Glomangiomyoma: glomus tumor and angioleiomyoma
- Glomus tumor of uncertain malignant potential: lots of mits, or >2cm or if found deep
- Glomangiosarcoma: Deep + >2cm or atypical mits or high nuclear grade; can met
Micro: branching vascular channels separated by stroma c glomus cells that are small, regular, round c no nucleoli seen in nests / aggregates ("string of black pearls"); glomus cells found around vessels (vessels can be HPC-like)
- more infiltrative in kiddos, but no mits
Cyto: cohesive clusters of uniform round cells c scanty cytoplasm
- background of scattered amorphous magent material, blood and occasional inflam cells
IHC: (+) SMA, MSA, type IV collage (pericellular), vimentin, CD34 (1/5), variable h-caldesmin / calponin
- negative cytokeratin, desmin, S100 and chromogranin
Tx: Excision
Glomus tumor


C, Glomus tumor shows small, uniform cells
Perivascular Epithelioid Cell Tumor (PEComa)
Perivascular clear cell and epithelial-like tumor that has melanocytic and muscle markers, 7F>>1M
- in the family of angiomyolipoma, clear cell "sugar" tumor of lung, clear cell myomelanocytic tumor of the falciform ligament, lymphangiomyomatosis (all assoc c tuberous sclerosis)
- deregulation of mTOR pathway (can tx c sirolimus or mTOR inhibitor)
Micro: perivascular tumor cells in nests and fascicles in radial shape around lumen, epithelial cells close to vessel, spindle cells farther away
- may not have perivascular pattern and look more clear cell-like in more undifferentiated cancers
IHC: (+) Melanoma and sm muscle markers, c-kit, cathepsin K, TFE3 (some, also seen in alveolar soft parts sarcoma), SMA, Desmin, S100
- neg CK, CD117, CD34
Genes:TSC1 (9q34), TSC2 (16p13.3)
- obvious abnormalities in most cases, some have rearrangement or amplification of TFE3
PEComa

Bacillary angiomatosis
see Infectious Dermatopathology
Angiokeratoma
A "bloody seb k" with hyperkeratosis, acanthosis and ectatic thin-walled vessels in epidermis
Atypical vascular lesion (AVL)
Is a specific dx, not just a description
- b9 vascular prolif post-rads
- clinically looks like flesh-colored papules arising in radiation site
- may be confused with well-diff angiosarc, and sometimes may occur adjacent to angiosarcoma
Micro: looks like lymphangioma, dermal prolif of infiltrating vascular channels that dissect bwt the collagen bundles
- can have some hyperchromasia
- does not have multilayering, does not have mits or pleomorphism/ atypia
- should be fairly superficial lesions, do not go deep
Genes: Negative for c-myc amplification (vs a post-radiation angiosarcoma)
Tx: controversial; but may be surgically excised although sometimes not feasible if there are many lesions
- ensuring adequate sampling of lesion is the most important issue (must avoid underdiagnosis of angiosarcoma)
- should be closely followed clinically (make sure that no new vascular lesions are developing)
Px: Usually b9 and does not progress to angiosarc (though exceptions do occur)

AVL


AVL vs AS

Angiosarcoma





Bland-appearing angiosarcoma with multilayered endotheliom that infiltrates (splits) through collagen

Angiosarcoma can have more solid, spindly areas



C, Epithelioid angiosarcoma demonstrates focal vasoformative features. The tumor is diffusely positive for CD31 (D) and Friend leukemia integration 1 transcription factor (FLI1) (E), with a variable CD34 expression (F) (hematoxylin-eosin; original magnification x20 [D through F]).
Angiosarcoma
Rare tumor in adults, (<1% of sarcomas), ~7th decade (very rare in kiddos) derived from endothelial cells of blood vessels that can occur in multiple sites depending on type of risk factor exposure
- skin>> breast > ST > solid organs > bone
- well differentiated (hemangiosarcoma) to anaplastic tumor that can look like melanoma or carcinoma
- risk factors: chronic lymphedema, PVC, radiation (esp breast), sun exposure, Thorotrast
- mets to node in 14%
- tumors do not arise in assoc c b9 hemangioma (though rarely epithelioid angiosarcoma arises in assoc c schwannoma)
Subtypes:
MC variant is cutaneous (40%, affecting sun-exposed areas of head and neck)
- radioation assoc angiosarcoma: in abdominal wall/cavity, Mullerian malignancy, >10 yrs after radiation; also in the skin of breast c breast cancer 3-5 years after radiation, incidence ~0.1%, can see irreg papules / plaques that are multicentric
- lymphedema assoc angiosarcoma - Stewart-Treves syndrome, chronic lymphedema, obesity assoc lymphedema (localized massive lymphedema, lymphangiomatosis is less likely precursor
- Primary breast angiosarcoma - women in 3rd or 4th decades; mass in breast parenchyma, overlying skin changes, ill-defined, destructive growth
- Soft tissue / Solid organ angiosarcoma - any age, ~1/3 syndromic (NF, Maffucci syndrome, Klippel-Trenaunay syndrome); predisposed by thoratrast, polyvinyl chloride, arsenic, foreign material (AV fistulas, shrapnel, plastics), epithelioid morphology, very poor px
-- Mass in Right Atrium = Angiosarcoma (until proven otherwise)
Gross: early on is sharply defined, asymptomatic multiple red nodules
- later is fleshy gray white c hemorrhage, necrosis and deeply invasive
Micro: atypical vascular spaced lined by endothelial cells c atypia and multilayering that involves subQ and has RBCs in intracytoplasmic lumina in more solid areas
- lots of mits and necrosis
IHC: (+) Factor 8 related peptide, CD31, Ki-67, FLI-1, thrombomodulin, CD34, c-kit, VEGFR-3, ERG, INI-1 (is lost in epithelioid sarcoma)
- occasionally stains for cytokeratins (CK18/7/8 in ~1/2)
- no loss of INI-1 (excludes epithelioid sarcoma)
Genes: high level MYC amplifications, esp in secondary tumors (post-radiation and in chronic lymphedema; not usually positive in primary sun damaged skin in elderly)
DDx: May mimic ecchymosis or solar purpura
- Kaposi can mimic angiosarc (and vice versa), they have totally different tx and px (Kaposi is usually not a surgical disease and is not fatal), should get HHV8 if there is any confusion
- epithelioid angiosarcoma can mimic other cancers (carcinoma, epithelioid sarcoma, melanoma) - epithelioid angiosarcoma often expreses keratins just like carcinoma and epithelioid sarcoma
- small biopsies may not be representative; if there is high suspicion, should repeat the biopsy!! Must communicate with clinician, and have higher index of suspicion if hx of lymphedema or radiation history
Tx: early aggressive surgery
- recurrence and progression still common since is a vascular lesion
- chemo and rads also used
- Sorafenib has a dramatic, although not a long-term effect
Px: poor survive past 5 years (<30%); most die in <12 mo after dx
- mets to lung and bone
Angiosarcoma blood lake

Kaposi sarcoma
Low grade endothelial malignancy that can be classic or AIDS assoc
- hyperhcromatic spindle cells c vascular slit pattern and extravasated RBCs
- HHV-8 plays role in all subtypes
Classic
Not assoc c HIV, old Mediteranean dudes, rare in US
Endemic
more rapid clinical course than classic disease
10% of all malig tumor central Africa, usually in young adults and kids;
- poor px if over 50 yo
HIV-assoc (epidemic)
derived from vasoformative mesenchymal multipotential cells
- can be mistaken for bacillary angiomatosis
- 75% involve the viscera in AIDS pts;
Iatrogenic
Transplants, immunosuppression
Micro: spindle cells forming slits c extravasated RBCs, hemosiderin laden macrophages, lymphs and fibrosis
- minimal atypia
- can have lots of PAS+ hyaline bodies, which are heme breakdown products
- moderate mits
Stages: Early-patch, later-plaque tumor, and nodular
- also a lymphanioma-like variant with thin, angulated vessels with no RBCs
Early-patch - bizarre staghorn vessels and plasma cells
Later-plaque - busy dermis surrounding adnexal structures and vessels
- Promontory sign - protrusion of pre-existing structues into lake-like ectatic space, leaves vessels looking like they are floating in space
Nodular - fascicles of spindle cells, separated by slit-like vascular spaces containing erythrocytes, PAS positive diastase resistant hyaline globules, extravasated RBCs, scattered plasma cells, and hemosiderin deposits
IHC: (+) CD34>CD31, factor VIII related antigen, podoplanin (D2-40), LANA (very sensitive and specific for HHV-8 infx)
- negative keratin and desmin
Genes: diploid and clonal
- HHV8 present in all types
Tx: radio chemo
Kaposi sarcoma



Kaposi sarcoma - early patch stage

from dermpedia.org
Kaposi sarcoma, nodular stage



Kaposi sarcoma hyaline globules (which are heme breakdown products) stained here with PAS
Lymphangiosarcoma
Lymphatic malignancy assoc c persistent lymphadema (after node dissection)
Venous lake
MC on lips and ears of elderly pts that blanch when compressed
Micro: Thin-walled ectatic vessel that collapses after bx
References
1. Jerad Gardner. Vascular Tumors of the Skin. YouTube video. https://www.youtube.com/watch?v=E5QQ3ZOJhoM
2.
